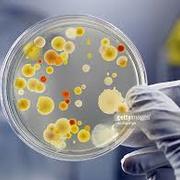

Learn Fiziologija
Study Fiziologija using smart web & mobile flashcards created by top students, teachers, and professors. Prep for a quiz or learn for fun!
Brainscape Certified flashcards
(0)
Decks
Flashcards
Learners
User Generated flashcards
(30)
Decks
Flashcards
Learners
-
Patologijos fiziologija
Patologijos fiziologija
By: Gerda J
Uždegimas1Decks48Flashcards2Learners -
Fiziologija
Fiziologija
By: Victoria S.
Kraujas1Decks47Flashcards2Learners -
Fiziologija
Fiziologija
By: Nika Nikić
Opća načela gastrointestinalne funkcije1Decks41Flashcards2Learners -
Fiziologija
Fiziologija
By: Kata Kurilj
Prijenos Tvari Kroz Membranu, Živčani Impuls, EEG ...4Decks70Flashcards1Learner -
Fiziologija
Fiziologija
By: Emilija Paukštytė
Spirometrija, Širdis, Spirometrija_23Decks20Flashcards2Learners -
Animalna fiziologija
Animalna fiziologija
By: martin perkovic
1. dio, FIZIOLOGIJA MEMBRANA I PRIJENOSNI MEHANIZMI2Decks47Flashcards1Learner -
VETERINARSKA FIZIOLOGIJA

VETERINARSKA FIZIOLOGIJA
By: ELIZABETA DOBRODEL
TROMBOCIT IN KOAGULACIJA, DIHANJE2Decks75Flashcards1Learner -
Fiziologija
Fiziologija
By: Maja Dekleva
1. predavanje, Dihala2Decks43Flashcards1Learner -
Fiziologija človeka
Fiziologija človeka
By: aestivalis 09
Stara vprašanja - izpit in kolokvij1Decks89Flashcards1Learner -
Fiziologija
Fiziologija
By: Isa Z
LEDVICE, Prebavila2Decks46Flashcards1Learner -
Obilježja Kolonija I Fiziologija Bakterija
Obilježja Kolonija I Fiziologija Bakterija
By: Luka Krvarić
Test 21Decks51Flashcards1Learner -
Fiziologija
Fiziologija
By: Akte XY
Kraujas1Decks55Flashcards1Learner -
Fiziologija 1

Fiziologija 1
By: Teodora Konic
Nervni sistem1Decks46Flashcards1Learner -
Patoloska Fiziologija
Patoloska Fiziologija
By: Milana Lana
Bubrezi, Srce2Decks34Flashcards1Learner -
Fiziologija
Fiziologija
By: Rugile Vasiliauskaite
1 paskaita + įvadas, Sinapsės2Decks35Flashcards1Learner -
Fiziologija parc
Fiziologija parc
By: Merima Kfsuihf
Krvne celije, imunost, i koagulacija krvi ( 32,33,34,35,36), Disanje, fiz u aviaciji, svemiru i ronjenju (37,38,39,40,41,42,43,44), Fiziologija digestivnog sistema (62,63,64,65,66) ...4Decks42Flashcards1Learner -
Fiziologija
Fiziologija
By: Lana Gregurić
Pitanja za ispit1Decks37Flashcards1Learner -
fiziologija mikrobov kolokvij

fiziologija mikrobov kolokvij
By: Anja Pungartnik
Vpliv dejavnikov okolja na rast mikroorganizmov, Adaptacija E .coli na anaerobiozo, Vpliv slanosti na metabolno aktivnost V. ruber ...4Decks23Flashcards1Learner -
fiziologija
fiziologija
By: djurdjija f
skeletni misici, srce2Decks26Flashcards1Learner -
fiziologija živali 1
fiziologija živali 1
By: Mihi Kobo
stuff1Decks28Flashcards1Learner -
Fiziologija
Fiziologija
By: Maja Dekleva
Celična fiziologija1Decks20Flashcards1Learner -
Patologinė fiziologija
Patologinė fiziologija
By: Valentina Marinionokaite
K1 LĄSTELĖS PAŽEIDIMŲ MORFOLOGIJA, K1 PRISITAIKYMO ARBA ADAPTACIJOS REAKCIJOS2Decks23Flashcards1Learner -
Patologinė fiziologija
Patologinė fiziologija
By: Rūta Radzevičiūtė
ketvirto kolio atviri1Decks20Flashcards1Learner -
Veterinary Science

Veterinary Science
By: Jure Jakomin
fiziologija prebave, fiziologija - energetski metabolizem in termoregulacija, parazitologija vaje ...26Decks5,043Flashcards212Learners -
BIOLOGIJA PRIPREME
BIOLOGIJA PRIPREME
By: Nina Mušatović
Opšta fiziologija, Fiziologija disanja, Fiziologija bubrega ...14Decks616Flashcards7Learners -
Sveikatos psichologija 2 pusmetis
Sveikatos psichologija 2 pusmetis
By: Deimantė .
BENDRAVIMO PSICHOLOGIJA NR1, Vokiečių, Fiziologija (tarpiniui - 2) ...11Decks1,173Flashcards2Learners -
Paramedikų kursas
Paramedikų kursas
By: Bober (kurwa)
Kompleksinis žmogaus kūno vertinimas ir komunikacija (Žmogaus anatomija, fiziologija, patologija - griaučių sistema), Kompleksinis žmogaus kūno vertinimas ir komunikacija (Žmogaus anatomija, fiziologija, patologija - kaukolė), Kompleksinis žmogaus kūno vertinimas ir komunikacija (Žmogaus anatomija, fiziologija, patologija - galūnių kaulai) ...13Decks450Flashcards2Learners -
anatomija
anatomija
By: ivana Unknown
latinski poimi, fiziologija?2Decks32Flashcards1Learner -
Biologija
Biologija
By: anja blaa
Molekularna, Fiziologija, Citologija ...7Decks575Flashcards9Learners -
patologija
patologija
By: Nicki Nočič
vprašanja patologija, fiziologija vprašanja2Decks348Flashcards1Learner



